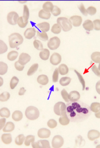

Haem: Paediatric haematology Flashcards
(61 cards)
Which feature of children predisposes them to nutrient deficiency?
Rapid growth
How is the immune response to infection different in children compared to adults?
Children are more likely to mount a lymphocytosis as they frequently encounter new pathogens
What are the main differences between the blood count of neonate and an adult?
- Higher WCC (neutrophils, lymphocytes)
- Higher Hb
- Higher MCV
How are the enzyme levels in the red blood cells of neonates different to adults?
They have 50% of the concentration of G6PD of adults
List some causes of polycythaemia in a foetus.
- Twin-to-Twin transfusion syndrome
- Intrauterine hypoxia
- Placental insufficiency
List some causes of anaemia in a foetus.
- Twin-to-Twin transfusion syndrome
- Foetal-to-Maternal transfusion
- Parvovirus infection
- Bleeding from cord or placenta
List some causes of damage to the red blood cells of a foetus.
- Irradiation
- Damage by something crossing the placenta (e.g. drugs, antibodies)
- Anticoagulants
- Substances in breast milk (e.g. fava beans in a baby with G6PD deficiency
When does the first mutation that leads to childhood leukaemia often occur?
In utero
Which condition is assocaited with congenital leukaemia?
Down syndrome
What is another term to describe congenital leukaemia?
Transient abnormal myelopoiesis (TAM)
Describe the usual course of congenital leukaemia.
- Remits spontaneously within the first 2 months of life
- However, 25% of infants will relapse after 1-2 years
- NOTE: the leukaemia is myeloid with major involvement of the megakaryocyte lineage
Define thalassaemia.
A group of conditions resulting from a reduced rate of synthesis of one or more globin chains as a result of a genetic defect.
Define haemoglobinopathy.
Refers to a structurally abnormal haemoglobin.
NOTE: thalassemias are sometimes considered a form of haemoglobinopathy
On which chromosomes are the different globin genes expressed?
Chromosone 11
- Beta
- Delta
- Gamma
- Epsilon
Chromosone 16
- 2x alpha
- Zeta
Which globin chains are found in the following types of haemoglobin:
- HbA
- HbA2
- HbF
- HbA = 2 alpha, 2 beta
- HbA2 = 2 alpha, 2 delta
- HbF = 2 alpha, 2 gamma
What is the normal HbA2 level in a healthy adult?
< 3.5%
Describe how the haemoglobin levels in utero change.
- Some specific foetal haemoglobins (epsilon, zeta etc) are present in the first 16 weeks
- HbF predominates throughout most of foetal life
- After around 32 weeks, there is a rapid increase in HbA production
- At birth, around 1/3 haemoglobin is HbA but this rapidly increases after birth
What is the difference between sickle cell anaemia and sickle cell disease?
- Sickle cell anaemia - homozygosity for HbS gene
- Sickle cell disease - encompasses homozygous and heterozygous states associated with sickling (including HbSC and HbS/beta thalassemia)
Outline the pathophysiology of sickle cell anaemia.
- Hypoxia leads to polymerisation of HbS leading to crescent-shaped red blood cells and blocker blood vessels
- This tends to occur in post-capillary venules
- When passing through these venules, red cells tend to elongate
- If the circulation slows down, cells will begin sickling and stickling to the endothelium causing obstruction
- Retrograde capillary obstruction results in arterial obstruction
- Early on, the sickling may be reversible by correcting the hypoxia
- However, the cells can become irreversibly sickled

What feature of hyposplenism might you seeon a blood film of a patient with sickle cell anaemia?
Howell Jolly bodies
Describe the severity of the following types of sickle cell disease:
- Sickle cell trait
- Sickle cell anaemia
- HbSC
- HbS/beta thalassemia
-
Sickle cell trait
- Usually asymptomatic
-
Sickle cell anaemia
- Manifests when HbF decreases and HbS increases (at 6 months age)
- Severe symptoms
-
HbSC
- Slightly milder than sickle cell anaemia
-
HbS/beta thalassemia
- Severity depends on whether it is beta-0 gene (no globin production) or beta+ gene (some globin production)
When is sickle cell anaemia usually diagnosed in the UK?
At birth following the Guthrie test
Why does sickle cell anaemia in a child differ from sickle cell anaemia in an adult?
- Mainly because the distribution of red bone marrow (contains haematopoietic precursors) differs
- Red bone marrow is vascular, metabolically active and susceptible to infarction
- Bone pain due to infarction is a prominent clinical feature in sickle cell anaemia
How is the pattern of bone pain due to infarction different in adults with sickle cell anaemia compared to children?
- Adults - only happens in central skeleton
- Infants/Children - can happen anywhere (including hands and feet causing hand-foot syndrome)
